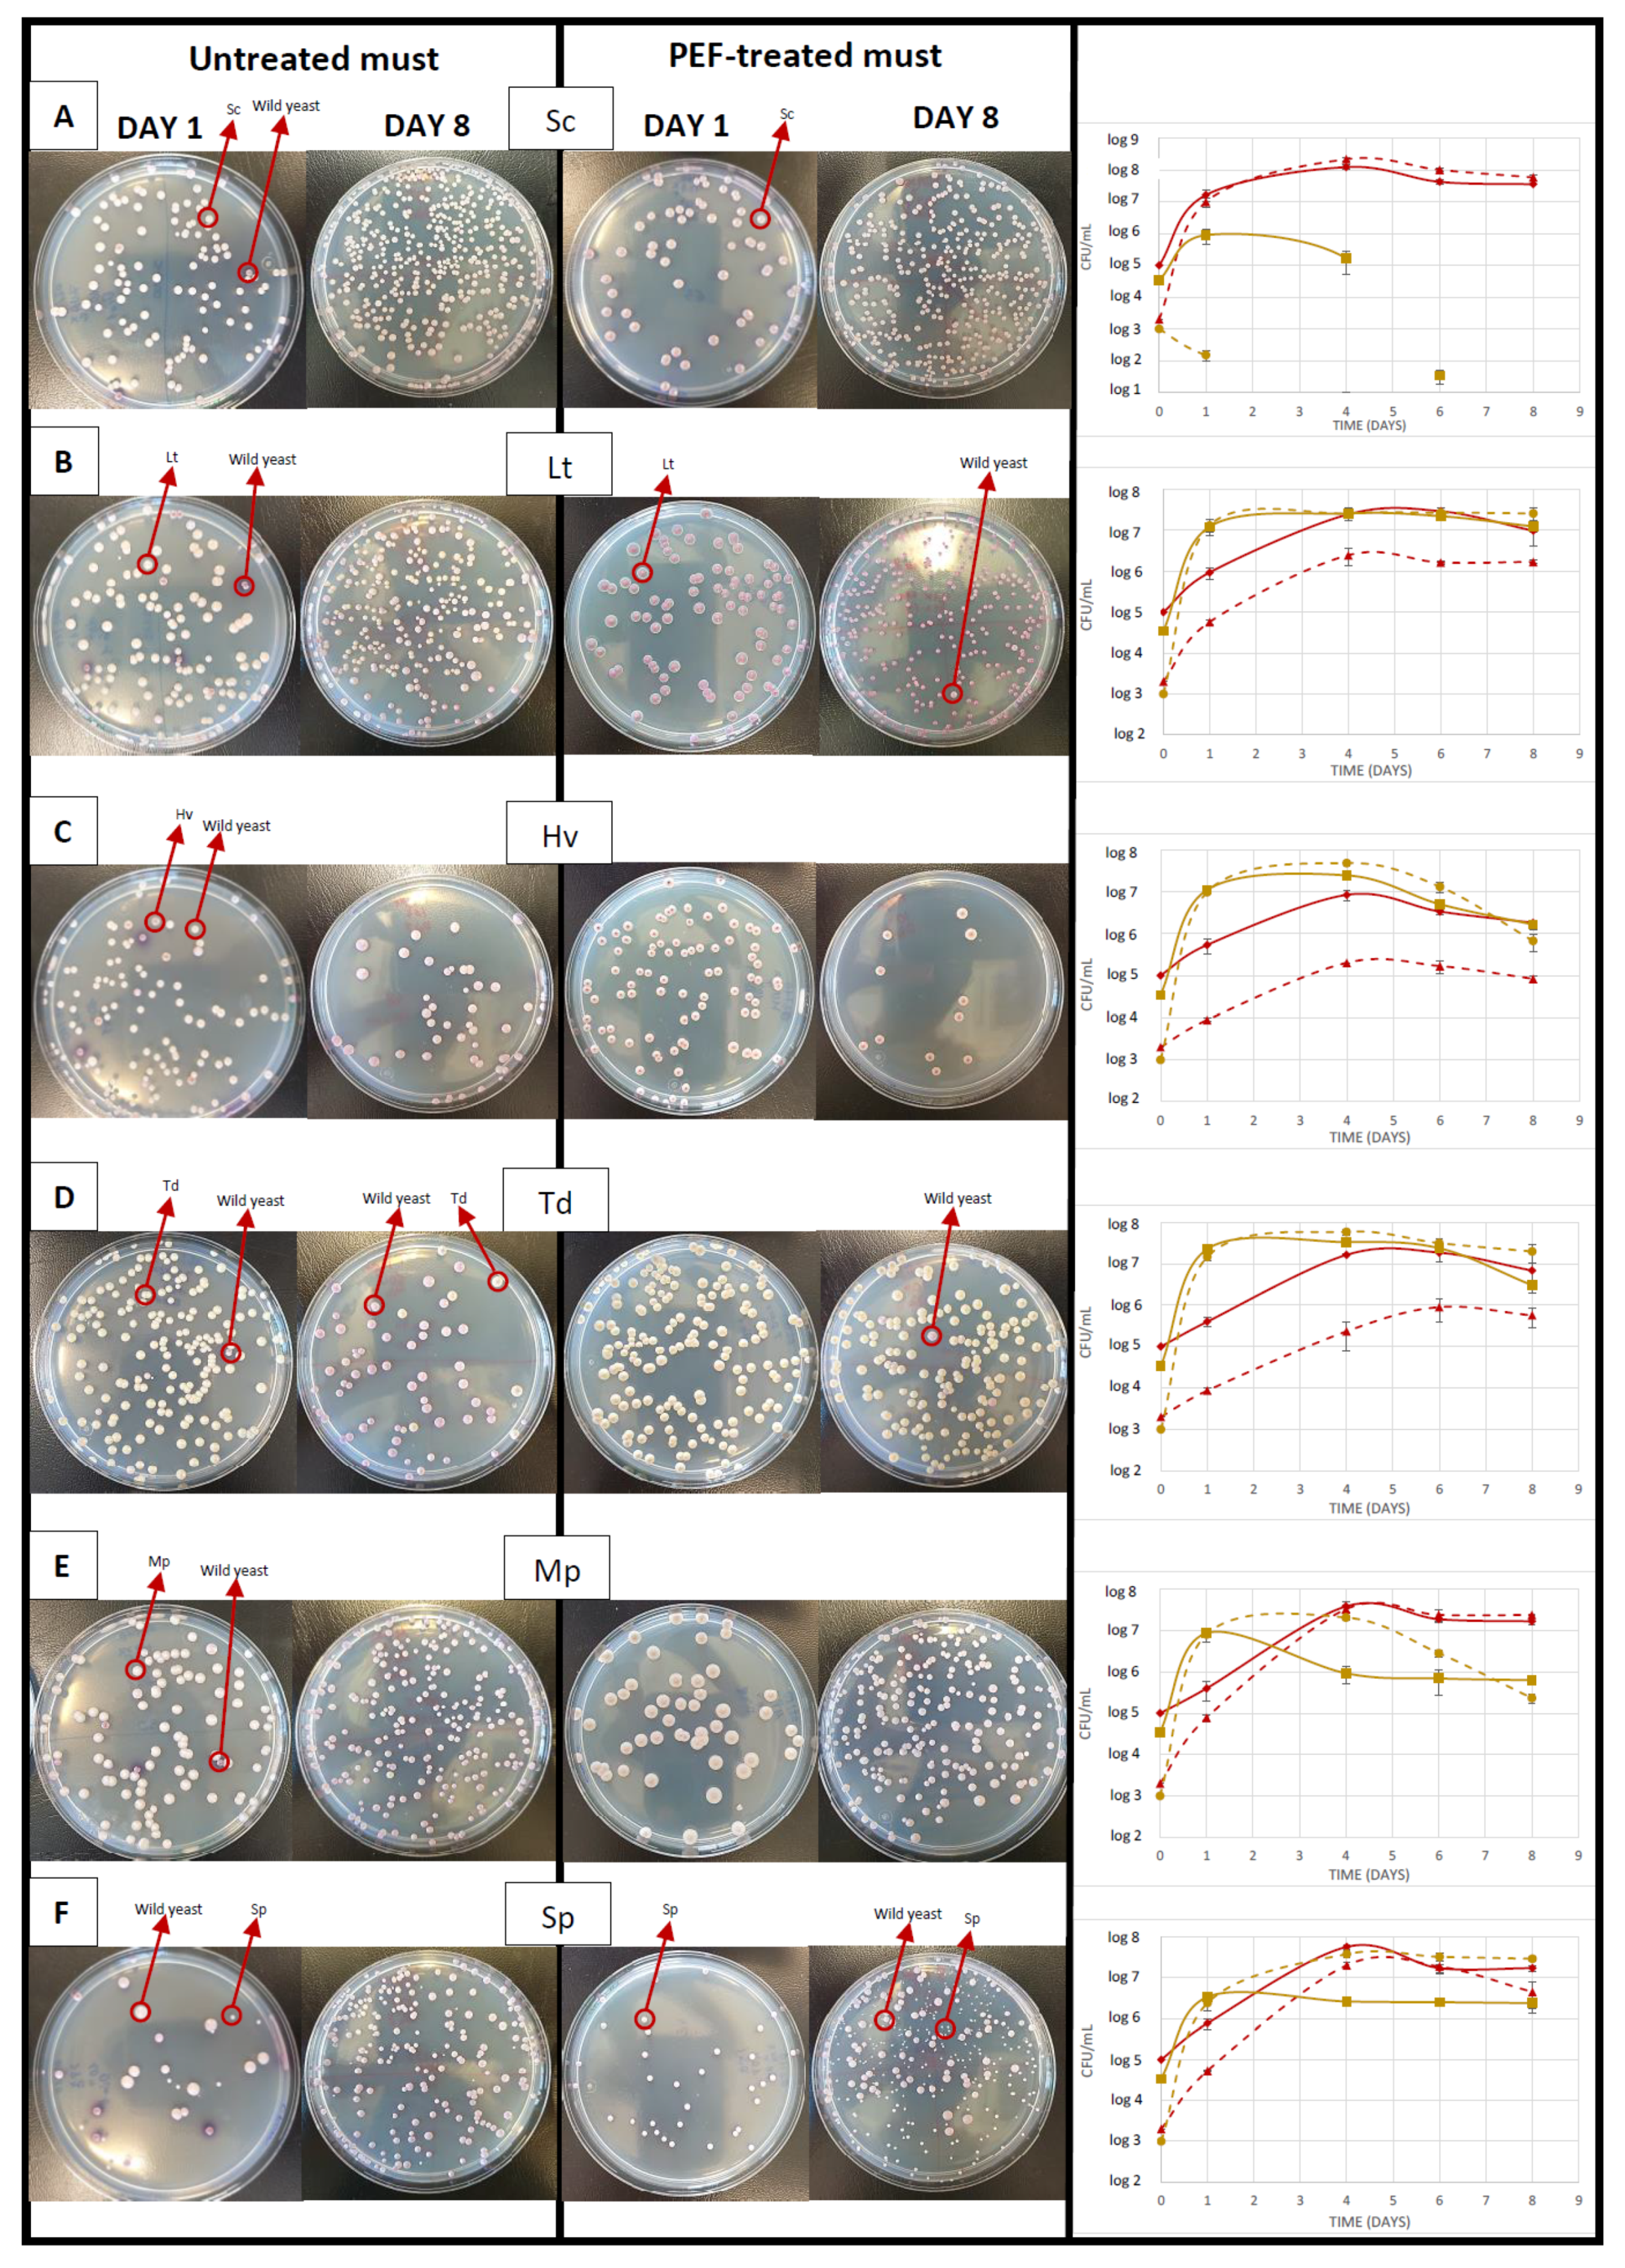
Foods 10 01472 g003 550

Pulsed Electric Fields to Improve the Use of Non-Saccharomyces Starters in Red Wines
Abstract
:1. Introduction
2. Materials and Methods
2.1. Grape Sample
2.2. PEF Processing
2.2.1. PEF Unit
2.2.2. PEF Processing of Grapes
2.2.3. PEF Processing of Must
2.3. Yeast Used
2.4. Fermentation Trials
2.5. Yeast Population Counts
2.6. Oenological Parameters
2.7. Analysis of Fermentative Volatile Compounds Using GC-FID
2.8. Determination of Anthocyanins
2.9. Sensory Analysis
2.10. Statistical Analysis
3. Results
3.1. Effects of PEF on the Extraction of Grenache Must after 24 h of Maceration
3.2. Antimicrobial Effect of PEF and Evolution of the Inoculated Population
3.3. Oenological Parameters
3.4. Lactic and Malic Acid
3.5. Fermentative Volatiles
3.6. Anthocyanins and Colour
3.7. Sensory Analysis
4. Discussion
5. Conclusions
Supplementary Materials
Author Contributions
Funding
Conflicts of Interest
References
- Kotnik, T.; Rems, L.; Tarek, M.; Miklavčič, D. Membrane Electroporation and Electropermeabilization: Mechanisms and Models. Annu. Rev. Biophys. 2019, 48, 63–91. [Google Scholar] [CrossRef]
- Barba, F.J.; Parniakov, O.; Pereira, S.A.; Wiktor, A.; Grimi, N.; Boussetta, N.; Saraiva, J.A.; Raso, J.; Martin-Belloso, O.; Witrowa-Rajchert, D.; et al. Current applications and new opportunities for the use of pulsed electric fields in food science and industry. Food Res. Int. 2015, 77, 773–798. [Google Scholar] [CrossRef]
- López-Giral, N.; González-Arenzana, L.; González-Ferrero, C.; López, R.; Santamaría, P.; Alfaro, I.L.; Garde-Cerdán, T. Pulsed electric field treatment to improve the phenolic compound extraction from Graciano, Tempranillo and Grenache grape varieties during two vintages. Innov. Food Sci. Emerg. Technol. 2015, 28, 31–39. [Google Scholar] [CrossRef]
- Leong, S.Y.; Burritt, D.J.; Oey, I. Evaluation of the anthocyanin release and health-promoting properties of Pinot Noir grape juices after pulsed electric fields. Food Chem. 2016, 196, 833–841. [Google Scholar] [CrossRef]
- Maza, M.A.; Martínez, J.M.; Hernández-Orte, P.; Cebrián, G.; Sánchez-Gimeno, A.C.; Álvarez, I.; Raso, J. Influence of pulsed electric fields on aroma and polyphenolic compounds of Garnacha wine. Food Bioprod. Process. 2019, 116, 249–257. [Google Scholar] [CrossRef]
- Ayuda, M.-I.; Ferrer-Pérez, H.; Pinilla, V. Explaining World Wine Exports in the First Wave of Globalization, 1848–1938. J. Wine Econ. 2020, 15, 263–283. Available online: https://www.cambridge.org/core/product/identifier/S1931436120000048/type/journal_article (accessed on 2 June 2020). [CrossRef]
- Cocolin, L.; Rantsiou, K.; Iacumin, L.; Zironi, R.; Comi, G. Molecular Detection and Identification of Brettanomyces/Dekkera bruxellensis and Brettanomyces/Dekkera anomalus in Spoiled Wines. Appl. Environ. Microbiol. 2004, 70, 1347–1355. Available online: https://aem.asm.org/content/70/3/1347 (accessed on 8 March 2004). [CrossRef] [Green Version]
- Stivala, M.G.; Villecco, M.B.; Enriz, D.; Aredes Fernández, P. Effect of Phenolic Compounds on Viability of Wine Spoilage Lactic Acid Bacteria. A Structure-Activity Relationship Study. Am. J. Enol. Vitic. 2017, 68, 228–233. [Google Scholar] [CrossRef]
- Garaguso, I.; Nardini, M. Polyphenols content, phenolics profile and antioxidant activity of organic red wines produced without sulfur dioxide/sulfites addition in comparison to conventional red wines. Food Chem. 2015, 179, 336–342. [Google Scholar] [CrossRef]
- Saldaña, G.; Puértolas, E.; López, N.; García, D.; Álvarez, I.; Raso, J. Comparing the PEF resistance and occurrence of sublethal injury on different strains of Escherichia coli, Salmonella Typhimurium, Listeria monocytogenes and Staphylococcus aureus in media of pH 4 and 7. Innov. Food Sci. Emerg. Technol. 2009, 10, 160–165. [Google Scholar] [CrossRef]
- Ricci, A.; Parpinello, G.P.; Versari, A. Recent Advances and Applications of Pulsed Electric Fields (PEF) to Improve Polyphenol Extraction and Color Release during Red Winemaking. Beverages 2018, 4, 18. Available online: https://www.mdpi.com/2306-5710/4/1/18 (accessed on 1 March 2018). [CrossRef] [Green Version]
- Delsart, C.; Grimi, N.; Boussetta, N.; Sertier, C.M.; Ghidossi, R.; Peuchot, M.M.; Vorobiev, E. Comparison of the effect of pulsed electric field or high voltage electrical discharge for the control of sweet white must fermentation process with the conventional addition of sulfur dioxide. Food Res. Int. 2015, 77, 718–724. [Google Scholar] [CrossRef]
- Morata, A.; Bañuelos, M.A.; Loira, I.; Raso, J.; Álvarez, I.; Garcíadeblas, B.; González, C.; Lepe, J.A.S. Grape Must Processed by Pulsed Electric Fields: Effect on the Inoculation and Development of Non-Saccharomyces Yeasts. Food Bioprocess Technol. 2020, 13, 1087–1094. [Google Scholar] [CrossRef]
- Vaquero, C.; Loira, I.; Bañuelos, M.A.; Heras, J.M.; Cuerda, R.; Morata, A. Industrial performance of several Lachancea thermotolerans strains for pH control in white wines from warm areas. Microorganisms 2020, 8, 830. Available online: https://www.mdpi.com/2076-2607/8/6/830 (accessed on 1 June 2020). [CrossRef] [PubMed]
- Muñoz-Redondo, J.M.; Puertas, B.; Cantos-Villar, E.; Jiménez-Hierro, M.J.; Carbú, M.; Garrido, C.; Ruiz-Moreno, M.J.; Moreno-Rojas, J.M. Impact of Sequential Inoculation with the Non-Saccharomyces T. delbrueckii and M. pulcherrima Combined with Saccharomyces cerevisiae Strains on Chemicals and Sensory Profile of Rosé Wines. J. Agric. Food Chem. 2021, 69, 1598–1609. [Google Scholar] [CrossRef] [PubMed]
- Drumonde-Neves, J.; Fernandes, T.; Lima, T.; Pais, C.; Franco-Duarte, R. Learning from 80 years of studies: A comprehensive catalogue of non-Saccharomyces yeasts associated with viticulture and winemaking. FEMS Yeast Res. 2021, 21, foab017. [Google Scholar] [CrossRef]
- Vaquero, C.; Loira, I.; Heras, J.M.; Carrau, F.; González, C.; Morata, A. Biocompatibility in Ternary Fermentations With Lachancea thermotolerans, Other Non-Saccharomyces and Saccharomyces cerevisiae to Control pH and Improve the Sensory Profile of Wines From Warm Areas. Front. Microbiol. 2021, 12, 656262. [Google Scholar] [CrossRef]
- Abalos, D.; Vejarano, R.; Morata, A.; González, C.; Suárez-Lepe, J.A. The use of furfural as a metabolic inhibitor for reducing the alcohol content of model wines. Eur. Food Res. Technol. 2011, 232, 663–669. [Google Scholar] [CrossRef]
- Loira, I.; Vejarano, R.; Morata, A.; Ricardo-Da-Silva, J.M.; Laureano, O.; Gonzalez, M.; Suárez-Lepe, J. Effect of Saccharomyces strains on the quality of red wines aged on lees. Food Chem. 2013, 139, 1044–1051. [Google Scholar] [CrossRef]
- Bañuelos, M.A.; Loira, I.; Escott, C.; Del Fresno, J.M.; Morata, A.; Sanz, P.D.; Otero, L.; Suárez-Lepe, J.A. Grape processing by high hydrostatic pressure: Effect on use of non-Saccharomyces in must fermentation. Food Bioprocess Technol. 2016, 9, 1769–1778. [Google Scholar] [CrossRef] [Green Version]
- Maza, M.A.; Pereira, C.; Martínez, J.M.; Camargo, A.; Álvarez, I.; Raso, J. PEF treatments of high specific energy permit the reduction of maceration time during vinification of Caladoc and Grenache grapes. Innov. Food Sci. Emerg. Technol. 2020, 63, 102375. [Google Scholar] [CrossRef]
- Ozturk, B.; Anli, E. Pulsed electric fields (PEF) applications on wine production: A review. BIO Web Conf. 2017, 9, 02008. [Google Scholar] [CrossRef]
- Puértolas, E.; López, N.; Condón, S.; Álvarez, I.; Raso, J. Potential applications of PEF to improve red wine quality. Trends Food Sci. Technol. 2010, 21, 247–255. Available online: https://linkinghub.elsevier.com/retrieve/pii/S0924224410000609 (accessed on 16 February 2010). [CrossRef]
- Kotnik, T.; Kramar, P.; Pucihar, G.; Miklavcic, D.; Tarek, M. Cell Membrane Electroporation—Part 1: The Phenomenon. IEEE Electr. Insul. Mag. 2012, 28, 14–23. Available online: http://ieeexplore.ieee.org/document/6268438/ (accessed on 16 August 2012). [CrossRef] [Green Version]
- Garde-Cerdán, T.; Marsellés-Fontanet, A.R.; Arias-Gil, M.; Ancín-Azpilicueta, C.; Martín-Belloso, O. Influence of SO2 on the evolution of volatile compounds through alcoholic fermentation of must stabilized by pulsed electric fields. Eur. Food Res. Technol. 2007, 227, 401–408. [Google Scholar] [CrossRef]
- Emanuel, E.; Dubrovin, I.; Hanya, E.; Pinhasi, G.A.; Pogreb, R.; Cahan, R. Eradication of Saccharomyces cerevisiae by Pulsed Electric Field Treatments. Microorganisms 2020, 8, 1684. Available online: https://www.mdpi.com/2076-2607/8/11/1684 (accessed on 29 October 2020). [CrossRef] [PubMed]
- Medina, K.; Boido, E.; Dellacassa, E.; Carrau, F. Growth of non-Saccharomyces yeasts affects nutrient availability for Saccharomyces cerevisiae during wine fermentation. Int. J. Food Microbiol. 2012, 157, 245–250. [Google Scholar] [CrossRef]
- Martin, V.; Valera, M.; Medina, K.; Boido, E.; Carrau, F. Oenological Impact of the Hanseniaspora/Kloeckera Yeast Genus on Wines—A Review. Fermentation 2018, 4, 76. Available online: https://www.mdpi.com/2311-5637/4/3/76 (accessed on 10 September 2018). [CrossRef] [Green Version]
- Morata, A.; Loira, I.; Tesfaye, W.; Bañuelos, M.; González, C.; Suárez Lepe, J. Lachancea thermotolerans Applications in Wine Technology. Fermentation 2018, 4, 53. Available online: https://www.mdpi.com/2311-5637/4/3/53 (accessed on 11 July 2018). [CrossRef] [Green Version]
- Canonico, L.; Agarbati, A.; Comitini, F.; Ciani, M. Torulaspora delbrueckii in the brewing process: A new approach to enhance bioflavour and to reduce ethanol content. Food Microbiol. 2016, 56, 45–51. [Google Scholar] [CrossRef]
- Canonico, L.; Comitini, F.; Ciani, M. Torulaspora delbrueckii for secondary fermentation in sparkling wine production. Food Microbiol. 2018, 74, 100–106. [Google Scholar] [CrossRef]
- Nardi, T.; Panero, L.; Petrozziello, M.; Guaita, M.; Tsolakis, C.; Cassino, C.; Vagnoli, P.; Bosso, A. Managing wine quality using Torulaspora delbrueckii and Oenococcus oeni starters in mixed fermentations of a red Barbera wine. Eur. Food Res. Technol. 2018, 245, 293–307. [Google Scholar] [CrossRef]
- Binati, R.L.; Innocente, G.; Gatto, V.; Celebrin, A.; Polo, M.; Felis, G.E.; Torriani, S. Exploring the diversity of a collection of native non-Saccharomyces yeasts to develop co-starter cultures for winemaking. Food Res. Int. 2019, 122, 432–442. [Google Scholar] [CrossRef]
- Morata, A.; Bañuelos, M.A.; Vaquero, C.; Loira, I.; Cuerda, R.; Palomero, F.; González, C.; Suárez-Lepe, J.A.; Wang, J.; Han, S.; et al. Lachancea thermotolerans as a tool to improve pH in red wines from warm regions. Eur. Food Res. Technol. 2019, 245, 885–894. [Google Scholar] [CrossRef]
- Loira, I.; Morata, A.; Palomero, F.; González, C.; Suárez-Lepe, J. Schizosaccharomyces pombe: A Promising Biotechnology for Modulating Wine Composition. Fermentation 2018, 4, 70. Available online: https://www.mdpi.com/2311-5637/4/3/70 (accessed on 23 August 2018). [CrossRef] [Green Version]
- Jolly, N.P.; Varela, C.; Pretorius, I.S. Not your ordinary yeast: Non- Saccharomyces yeasts in wine production uncovered. FEMS Yeast Res. 2014, 14, 215–237. [Google Scholar] [CrossRef] [Green Version]
- Esteve-Zarzoso, B.; Manzanares, P.; Ramón, D.; Querol, A. The role of non-Saccharomyces yeasts in industrial winemaking. Int. Microbiol. 1998, 1, 143–148. Available online: http://www.ncbi.nlm.nih.gov/pubmed/10943352 (accessed on 1 June 1998).
- Petitgonnet, C.; Klein, G.L.; Roullier-Gall, C.; Schmitt-Kopplin, P.; Quintanilla-Casas, B.; Vichi, S.; Julien-David, D.; Alexandre, H. Influence of cell-cell contact between L. thermotolerans and S. cerevisiae on yeast interactions and the exo-metabolome. Food Microbiol. 2019, 83, 122–133. [Google Scholar] [CrossRef] [PubMed]
- Rapp, A.; Versini, G. Influence of nitrogen compounds in grapes on aroma compounds of wines. Dev. Food Sci. 1995, 37, 1659–1694. Available online: https://linkinghub.elsevier.com/retrieve/pii/S0167450106802578 (accessed on 2 September 2007).
- Balikci, E.K.; Tanguler, H.; Jolly, N.P.; Erten, H. Influence of Lachancea thermotolerans on cv. Emir wine fermentation. Yeast 2016, 33, 313–321. [Google Scholar] [CrossRef] [PubMed] [Green Version]
- Gobbi, M.; Comitini, F.; Domizio, P.; Romani, C.; Lencioni, L.; Mannazzu, I.; Ciani, M. Lachancea thermotolerans and Saccharomyces cerevisiae in simultaneous and sequential co-fermentation: A strategy to enhance acidity and improve the overall quality of wine. Food Microbiol. 2013, 33, 271–281. [Google Scholar] [CrossRef]
- Bartowsky, E.J.; Henschke, P.A. The ‘buttery’ attribute of wine—diacetyl—desirability, spoilage and beyond. Int. J. Food Microbiol. 2004, 96, 235–252. Available online: https://linkinghub.elsevier.com/retrieve/pii/S0168160504002867 (accessed on 1 August 2004). [CrossRef] [PubMed]
- Rogerson, F.S.S.; Castro, H.; Fortunato, N.; Azevedo, Z.; Macedo, A.; De Freitas, V.A.P. Chemicals with sweet aroma descriptors found in Portuguese wines from the Douro region: 2,6,6-Trimethylcyclohex-2-ene-1,4-dione and diacetyl. J. Agric. Food Chem. 2000, 49, 263–269. [Google Scholar] [CrossRef] [PubMed]
- Carrau, F.M.; Medina, K.; Farina, L.; Boido, E.; Henschke, P.A.; Dellacassa, E. Production of fermentation aroma compounds by Saccharomyces cerevisiae wine yeasts: Effects of yeast assimilable nitrogen on two model strains. FEMS Yeast Res. 2008, 8, 1196–1207. [Google Scholar] [CrossRef] [Green Version]
- Sgouros, G.; Mallouchos, A.; Filippousi, M.; Banilas, G.; Nisiotou, A. Molecular Characterization and Enological Potential of A High Lactic Acid-Producing Lachancea thermotolerans Vineyard Strain. Foods 2020, 9, 595. Available online: https://www.mdpi.com/2304-8158/9/5/595 (accessed on 7 May 2020). [CrossRef] [PubMed]
- Peinado, R.A.; Moreno, J.; Medina, M.; Mauricio, J.C. Changes in volatile compounds and aromatic series in sherry wine with high gluconic acid levels subjected to aging by submerged flor yeast cultures. Biotechnol. Lett. 2004, 26, 757–762. [Google Scholar] [CrossRef]
- Xu, Y.; Wang, D.; Li, H.G.; Hao, J.; Jiang, W.; Liu, Z.; Qin, Q. Flavor Contribution of Esters in Lager Beers and an Analysis of Their Flavor Thresholds. J. Am. Soc. Brew. Chem. 2017, 75, 201–206. [Google Scholar] [CrossRef]
- Zhang, B.; Xu, D.; Duan, C.; Yan, G. Synergistic effect enhances 2-phenylethyl acetate production in the mixed fermentation of Hanseniaspora vineae and Saccharomyces cerevisiae. Process. Biochem. 2020, 90, 44–49. [Google Scholar] [CrossRef]
- Viana, F.; Taillandier, P.; Valles, S.; Strehaiano, P.; Manzanares, P. 2-Phenylethyl Acetate Formation by Immobilized Cells of Hanseniaspora vineae in Sequential Mixed Fermentations. Am. J. Enol. Vitic. 2011, 62, 122–126. [Google Scholar] [CrossRef]
- Donsì, F.; Ferrari, G.; Fruilo, M.; Pataro, G. Pulsed Electric Field-Assisted Vinification of Aglianico and Piedirosso Grapes. J. Agric. Food Chem. 2010, 58, 11606–11615. [Google Scholar] [CrossRef] [PubMed]
- Loira, I.; Morata, A.; Comuzzo, P.; Callejo, M.J.; González, C.; Calderón, F.; Suárez-Lepe, J.A. Use of Schizosaccharomyces pombe and Torulaspora delbrueckii strains in mixed and sequential fermentations to improve red wine sensory quality. Food Res. Int. 2015, 76, 325–333. [Google Scholar] [CrossRef]
- Morata, A.; Gómez-Cordovés, M.C.; Colomo, B.; Suárez, J.A. Pyruvic Acid and Acetaldehyde Production by Different Strains of Saccharomyces cerevisiae: Relationship with Vitisin A and B Formation in Red Wines. J. Agric. Food Chem. 2003, 51, 7402–7409. [Google Scholar] [CrossRef]
- Morata, A.; Benito, S.; Loira, I.; Palomero, F.; González, M.C. Formation of pyranoanthocyanins by Schizosaccharomyces pombe during the fermentation of red must. Int. J. Food Microbiol. 2012, 159, 47–53. [Google Scholar] [CrossRef] [PubMed]
- Figueiredo-González, M.; Cancho-Grande, B.; Simal-Gándara, J.; Teixeira, N.; Mateus, N.; De Freitas, V. The phenolic chemistry and spectrochemistry of red sweet wine-making and oak-aging. Food Chem. 2014, 152, 522–530. Available online: https://linkinghub.elsevier.com/retrieve/pii/S0308814613018736 (accessed on 9 December 2013). [CrossRef] [PubMed]
- Yang, N.; Huang, K.; Lyu, C.; Wang, J. Pulsed electric field technology in the manufacturing processes of wine, beer, and rice wine: A review. Food Control 2016, 61, 28–38. [Google Scholar] [CrossRef]

| Oenological Parameters | |
|---|---|
| pH | 3.65 ± 0.02 |
| Brix (g/L) | 25.5 ± 0.21 |
| Total acidity (g/L) | 4.27 ± 0.08 |
| Colour intensity | 17.64 ± 0.10 |
| Total phenol index (280 nm) | 45.3 ± 0.28 |
| Anthocyanins (mg/L) | 522.3 ± 24.0 |
| Tannins (mg/L) | 104.5 ± 13.8 |
| Parameters | Ethanol (% v/v) | Total Acidity (g/L) | Volatile Acidity (g/L) | Glucose/Fructose (g/L) | pH | |||||
|---|---|---|---|---|---|---|---|---|---|---|
| Yeast/Days | 8 | 20 | 8 | 20 | 8 | 20 | 8 | 20 | 8 | 20 |
| Sc Untreated | 15.20 ± 0.00 g | 15.20 ± 0.10 f | 4.33 ± 0.06 e | 3.87 ± 0.06 c | 0.07 ± 0.00 a | 0.09 ± 0.01 a | 0.30 ± 0.00 a | 0.13 ± 0.23 ab | 3.38 ± 0.01 cd | 3.55 ± 0.01 def |
| Sc PEF | 15.20 ± 0.10 g | 15.10 ± 0.10 d ef | 4.37 ± 0.06ef | 3.93 ± 0.06 cd | 0.08 ± 0.02 ab | 0.09 ± 0.01 ab | 0.00 ± 0.00 a | 0.00 ± 0.00 a | 3.40 ± 0.01 de | 3.55 ± 0.01 def |
| Lt Untreated | 14.00 ± 0.00 c | 14.97 ± 0.06 cd | 4.90 ± 0.10 g | 4.77 ± 0.06 f | 0.17 ± 0.01 e | 0.15 ± 0.01 c | 23.60 ± 1.90 e | 0.30 ± 0.36 ab | 3.30 ± 0.02b | 3.38 ± 0.01 b |
| Lt PEF | 12.10 ± 0.10 a | 14.70 ± 0.10 b | 5.50 ± 0.17 h | 5.37 ± 0.29 g | 0.33 ± 0.03 h | 0.34 ± 0.06 e | 51.10 ± 0.87 g | 3.47 ± 0.85 f | 3.13 ± 0.02 a | 3.19 ± 0.09 a |
| Hv Untreated | 14.43 ± 0.15 e | 15.03 ± 0.12 cde | 4.00 ± 0.00 bc | 3.93 ± 0.06 cd | 0.25 ± 0.02 g | 0.23 ± 0.02 d | 18.17 ± 3.25 d | 0.80 ± 0.17 bc | 3.44 ± 0.01 fg | 3.49 ± 0.00 c |
| Hv PEF | 13.47 ± 0.15 b | 14.37 ± 0.12 a | 3.63 ± 0.15 a | 3.37 ± 0.06 a | 0.31 ± 0.02 h | 0.31 ± 0.01 e | 33.00 ± 2.52 f | 15.73 ± 0.70 g | 3.49 ± 0.02 h | 3.58 ± 0.01 ef |
| Td Untreated | 14.50 ± 0.10 e | 15.03 ± 0.06 cde | 4.33 ± 0.06 e | 4.13 ± 0.06 e | 0.11 ± 0.02 cd | 0.11 ± 0.00 ab | 13.33 ± 0.45 c | 1.90 ± 0.35 de | 3.42 ± 0.02 ef | 3.47 ± 0.01 c |
| Td PEF | 14.23 ± 0.15 d | 14.93 ± 0.06 c | 3.90 ± 0.17 b | 3.60 ± 0.17 b | 0.12 ± 0.02 cd | 0.11 ± 0.01 ab | 16.80 ± 3.02 cd | 2.13 ± 0.21 e | 3.47 ± 0.02 h | 3.59 ± 0.02 f |
| Mp Untreated | 14.77 ± 0.06 f | 15.10 ± 0.00 def | 4.50 ± 0.00 f | 4.20 ± 0.00 e | 0.13 ± 0.01 d | 0.12 ± 0.01 abc | 8.90 ± 1.55 b | 1.23 ± 0.87 cd | 3.36 ± 0.01 c | 3.45 ± 0.01 c |
| Mp PEF | 13.33 ± 0.06 b | 15.00 ± 0.10 cd | 4.13 ± 0.06 cd | 4.10 ± 0.00 de | 0.21 ± 0.01 f | 0.15 ± 0.01 c | 32.07 ± 0.93 f | 0.80 ± 0.44 bc | 3.40 ± 0.01 de | 3.49 ± 0.00 c |
| Sp Untreated | 14.90 ± 0.10 f | 15.17 ± 0.12 ef | 3.70 ± 0.00 a | 3.37 ± 0.06 a | 0.10 ± 0.01 bc | 0.12 ± 0.01 bc | 7.07 ± 4.80 b | 0.00 ± 0.00 a | 3.45 ± 0.01 g | 3.54 ± 0.01 d |
| Sp PEF | 14.47 ± 0.06 e | 14.97 ± 0.12 cd | 4.17 ± 0.06 d | 3.63 ± 0.06 b | 0.22 ± 0.02 f | 0.21 ± 0.02 d | 9.40 ± 1.78 b | 0.03 ± 0.06 ab | 3.40 ± 0.02 de | 3.54 ± 0.00 de |
| Parameters | Colour Intensity | Tonality | TPI | |||
|---|---|---|---|---|---|---|
| Yeast/Day | Day 0 | Day 20 | Day 0 | Day 20 | Day 0 | Day 20 |
| Sc Untreated | 17.64 ± 0.10 b | 6.02 ± 0.26 d | 6.33 ± 0.10 a | 5.52 ± 0.30 c | 45.9 ± 0.10 a | 27.3 ± 0.82 cdef |
| Lt Untreated | 6.94 ± 0.20 e | 4.93 ± 0.27 a | 24.7 ± 0.49 a | |||
| Hv Untreated | 5.99 ± 0.15 d | 6.44 ± 0.18 h | 27.7 ± 0.31 def | |||
| Td Untreated | 5.74 ± 0.12 bcd | 5.70 ± 0.14 de | 27.2 ± 0.35 cde | |||
| Mp Untreated | 6.81 ± 0.21 e | 6.59 ± 0.26 h | 28.8 ± 0.12 g | |||
| Sp Untreated | 5.71 ± 0.17 bcd | 5.46 ± 0.25 bc | 27.0 ± 0.10 c | |||
| Sc PEF | 16.92 ± 0.20 a | 5.05 ± 0.05 a | 6.32 ± 0.20 a | 5.31 ± 0.06 b | 47.9 ± 0.20 b | 26.1 ± 0.31 b |
| Lt PEF | 6.09 ± 0.08 d | 5.54 ± 0.08 cd | 27.1 ± 0.39 cd | |||
| Hv PEF | 5.88 ± 0.07 cd | 6.15 ± 0.08 g | 28.4 ± 0.39 fg | |||
| Td PEF | 5.41 ± 0.03 ab | 5.57 ± 0.04 cde | 26.1 ± 0.29 b | |||
| Mp PEF | 5.75 ± 0.25 bcd | 5.72 ± 0.29 e | 27.8 ± 0.11 ef | |||
| Sp PEF | 5.46 ± 0.22 abc | 5.97 ± 0.26 f | 28.0 ± 0.22 f | |||
Publisher’s Note: MDPI stays neutral with regard to jurisdictional claims in published maps and institutional affiliations. |
© 2021 by the authors. Licensee MDPI, Basel, Switzerland. This article is an open access article distributed under the terms and conditions of the Creative Commons Attribution (CC BY) license (https://creativecommons.org/licenses/by/4.0/).
Share and Cite
Vaquero, C.; Loira, I.; Raso, J.; Álvarez, I.; Delso, C.; Morata, A. Pulsed Electric Fields to Improve the Use of Non-Saccharomyces Starters in Red Wines. Foods 2021, 10, 1472. https://doi.org/10.3390/foods10071472
Vaquero C, Loira I, Raso J, Álvarez I, Delso C, Morata A. Pulsed Electric Fields to Improve the Use of Non-Saccharomyces Starters in Red Wines. Foods. 2021; 10(7):1472. https://doi.org/10.3390/foods10071472
Chicago/Turabian StyleVaquero, Cristian, Iris Loira, Javier Raso, Ignacio Álvarez, Carlota Delso, and Antonio Morata. 2021. "Pulsed Electric Fields to Improve the Use of Non-Saccharomyces Starters in Red Wines" Foods 10, no. 7: 1472. https://doi.org/10.3390/foods10071472
APA StyleVaquero, C., Loira, I., Raso, J., Álvarez, I., Delso, C., & Morata, A. (2021). Pulsed Electric Fields to Improve the Use of Non-Saccharomyces Starters in Red Wines. Foods, 10(7), 1472. https://doi.org/10.3390/foods10071472

